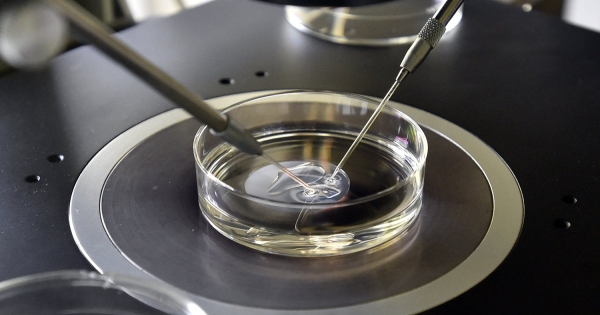
Lombikprogram: a munkajogi védelem keretei

Lombikprogram: a munkajogi védelem keretei
- 2017. június 13.
Könyvelő hírfigyelő
- adozona.hu
Az emberi reprodukciós eljárásban, vagy ahogyan a köznyelvben összefoglalóan hívjuk, a lombikprogramban résztvevő párok száma sajnos napról-napra nő. Bár a munkajogi szabályok biztosítják a védelmet, mégsem annyira egyértelműek, mint várandósság esetén. Meddig tart egy eljárás? Az mikor minősül befejezettnek? Két kezelés között, illetve minden egyes megkezdett eljárás esetén jár védelem?
